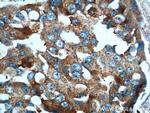
PRELID1 Antibody in Immunohistochemistry (Paraffin) (IHC (P))

Search
Proteintech
PRELID1 Polyclonal Antibody
{{$productOrderCtrl.translations['antibody.pdp.commerceCard.promotion.promotions']}}
{{$productOrderCtrl.translations['antibody.pdp.commerceCard.promotion.viewpromo']}}
{{$productOrderCtrl.translations['antibody.pdp.commerceCard.promotion.promocode']}}: {{promo.promoCode}} {{promo.promoTitle}} {{promo.promoDescription}}. {{$productOrderCtrl.translations['antibody.pdp.commerceCard.promotion.learnmore']}}
产品信息
10877-1-AP
种属反应
宿主/亚型
分类
类型
抗原
偶联物
形式
浓度
规格
纯化类型
保存液
内含物
保存条件
运输条件
产品详细信息
Immunogen sequence: MVKYFLGQS VLRSSWDQVF AAFWQRYPNP YSKHVLTEDI VHREVTPDQK LLSRRLLTKT NRMPRWAERL FPANVAHSVY VLEDSIVDPQ NQTMTTFTWN INHARLMVVE ERCVYCVNSD NSGWTEIRRE AWVSSSLFGV SRAVQEFGLA RFKSNVTKTM KGFEYILAKL QGEAPSKTLV ETAKEAKEKA KETALAATEK AKDLASKAAT KKQQQQQQFV (1-219 aa encoded by BC008307)
靶标信息
May be important for the development of vital and immunocompetent organs.
仅用于科研。不用于诊断过程。未经明确授权不得转售。
生物信息学
蛋白别名: 25 kDa protein of relevant evolutionary and lymphoid interest; PRELI domain-containing protein 1, mitochondrial; protein of relevant evolutionary and lymphoid interest; PX19 homolog; Px19-like protein; unnamed protein product
基因别名: 2610524G07Rik; CGI-106; PRELI; PRELID1; PX19; RGD1308082; SBBI12
UniProt ID: (Human) Q9Y255, (Mouse) Q8R107
Entrez Gene ID: (Human) 27166, (Rat) 290995, (Mouse) 66494